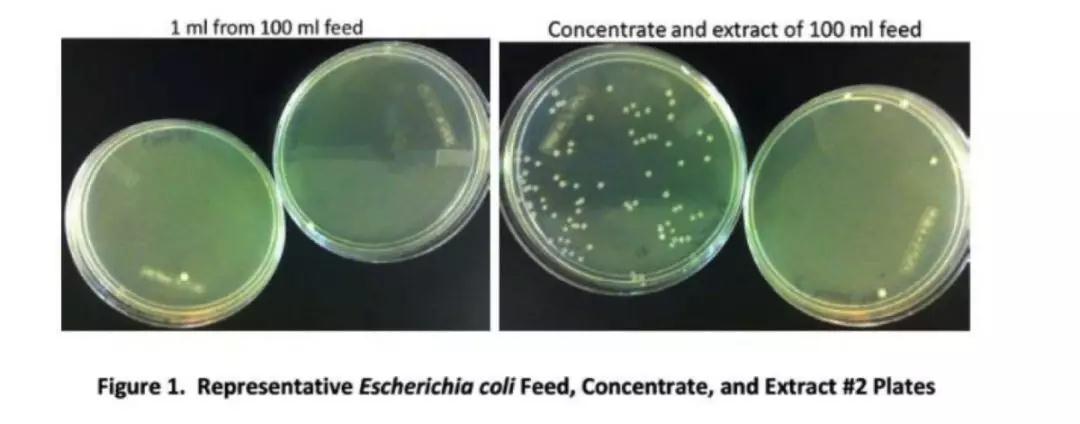

2020年2月3日,武汉大学中南医院影像科副主任张笑春发了一条朋友圈:“别迷信核酸检测了,强烈推荐 CT 影像作为目前 2019-nCoV 肺炎主要依据”,并称这是“一个一线影像医生的大声疾呼!”
典型案例
天津一女性感染病例,1 月 21 日出现发热后,前后共做了三次核酸检测均呈阴性,2月1日第四次检测后才呈阳性。
2020年2月5日,国家卫健委发布《新型冠状病毒感染的肺炎诊疗方案(试行第五版)》。其中最主要的一个变化是,将湖北省和其他省份的诊断分类标准区分开来。在湖北省,将原本的疑似病例标准拆分,原本的“老三条”:发热、白细胞或淋巴细胞减少,以及肺部CT影像,被一分为二,只要满足前两条即可视为“疑似”,相当于放宽了疑似标准。但同时,将第三条肺部CT表现视为“临床诊断”,为湖北新增的一类诊断类别。确诊标准则没有改变,仍是试剂盒检测阳性和基因测序与新冠病毒同源。
张笑春后来发文回应称,并非否定核酸检测结果,而是认为其作为检测的最终手段,目前仍受到产量、采样方式等限制,武汉无法在现阶段完全依赖核酸检测去筛查病人,达到切断传染源的防控效果。到此,CT和试剂盒的争论暂时画上了句号。
到现在,我们已清楚地知道,确诊的手段是新冠病毒核酸检测阳性,摆在我们面前的是,如何提升它的检测能力,我们知道核酸检测环节多,包括:样品采集、核酸提取、试剂检测。每一个环节都很重要,下面就样品采集这一环节谈谈目前情况下的制肘。
在新冠病毒核酸检测中,有一个起关键作用的步骤,就是样品采集,为什么呢?我们来看看以下分析:
据临床样本分析,新冠病毒在人体咽部、痰液、肺的病毒含量是由低到高,下图也展示了不同部位的一个采集方法,以及方法比较。最有效的是采集肺泡灌洗液,但由于临床路径太复杂了,受到了一定的局限性。

肺泡灌洗液(BACF)采集的临床路径:

(注:上图BACF采集是收集肺灌洗液)
所以结论是:对于疑似患者的筛查工作,目前咽拭子采集是最可行的方法。同时也带来一个疑问:

成熟的咽拭子采集方法为什么就变得力不从心呢,成为核酸检测漏检的影响因素?
我们知道,尽管咽拭子采集具有很多的优越性,但也由于疫情的急迫,效果打了个“折扣”,下来我们来看看:
人手不足:目前等待核酸检测人数大大超过检测能力,面对检测量超负荷的状态下,专业人员数量显得捉襟见肘,熟练化的人员更不够。每个医护人员划的轻重,多少都不一样。
采集难度大:这次疫情的医护人员必须采取三级防护措施,穿着厚重又严密的防护服,要实现精准采样,难度很大。
还有一个客观因素,咽拭子作为最普遍的采样方式,本来病毒基数低,加上采样手法的差异、操作难度的加大,很多病人咽拭子阴性,但肺泡里有病毒。

针对上面的困难,针对上面的困难,我们也提出了解决方案:
增挼更多的医护人员;
去掉作为医护人员生命防线的防护服,保证采样质量;
提高采样病毒量。
但是,对于医护人员人手方面,目前来说增挼也是有限的,况且核酸检测全过程对人员操作要求高,马上培训合格上岗,时间不允许;同时,医护人员处在最前线,去掉他们的防护服显然也不可能,那么,把希望都落到了提高采样病毒量,元芳怎样看,如何就有限的病毒量提高检测效率呢?
显然,提高检测病毒量这是可操作性最大的一个方向,摆在我们面前,有三条路:

得到一致的共识是:
①路径一行不通,前面已经分析过,目前情况下很难保证采样的质量,要么换其他采集方式。
②路径二是可行的,是对样本进行浓缩富集,在有限的病毒量提高利用率。
③路径三考虑的是多次咽拭子采集,混合一起浓缩富集,有效的避免单次操作的不稳定性,相对路径二,更为科学有效的筛查方案。
所以,浓缩富集,对于提高检测效率,既科学又有效!
我们来看两个案例,关于浓缩富集后带来的提效。
美国CDC对环境中病毒的收集与检测,将气溶胶样品汇集并用CP Select进行H7N2检测。在InnovaPrep浓缩移液管中将混合样本K01、K02和K08的A(H7N2)卵接种量增加约33倍,导致M1拷贝数增加47倍。同样地,浓缩样品K03大约22倍导致M1拷贝急剧增加2x107-8倍,并使血凝检测成为可能,最终HA滴度为512HA单位(HAU)/50_l尿囊液”。

下图左边是从100ml样品中取1ml检测结果;右边是将100ml样品浓缩后取样检测结果。浓缩富集可以大大改善检测限,降低漏检风险,确保结果稳定可靠。几分钟可得到高浓缩液体样本,再用PCR等快检方法几个小时得到结果。
目前我司提供的病毒浓缩富集系统解决方案:CP Select,可以通过视频了解到,几分钟时间就可以把几百毫升的液体浓缩至几百微升。
该设备具有以下优点:
10万倍以上的无损浓缩,浓缩后体积减少至几百微升;
3分钟浓缩1L液体中的病毒至几百微升,直接PCR或测序仪等,几小时出结果;
多样品富集成一个,上机可以提高检出率的同时提高效率和减少试剂成本;
快速完成低浓度固、液体浓缩至高浓度液体制备样,非常适用于呼吸道病毒、肠道病毒等病原微生物监测。

相对传统方法我们能够做到成倍的增加痕量检测的可能性,同时大大减少时间和劳动力。
在致敬一线医护人员的同时,
我们检测人希望在抗击疫情战斗中,
贡献出一份力量,
众志成城,共度时艰。



